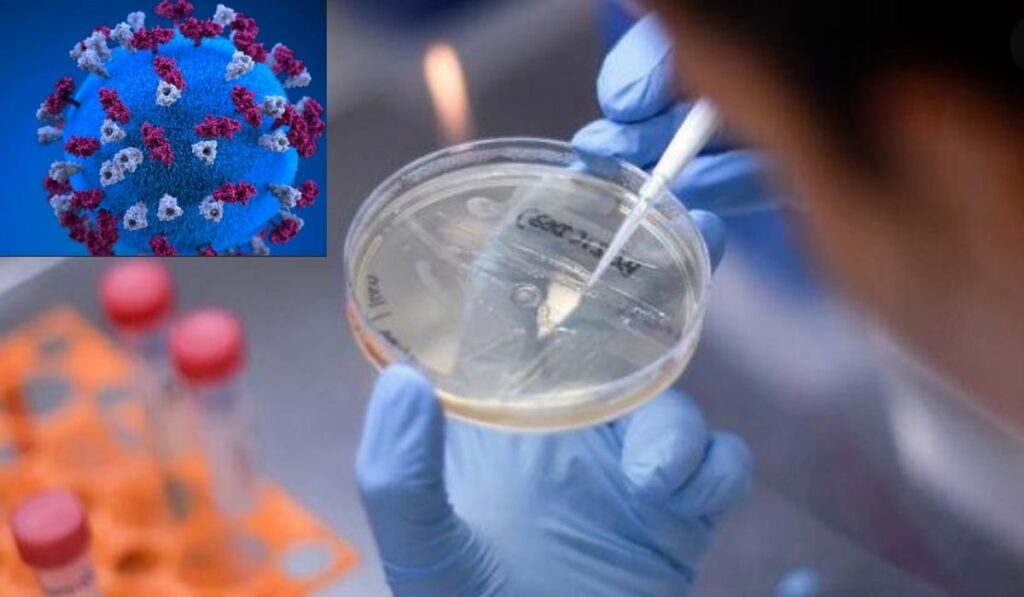
La nueva variante C.1.2 que descubrieron científicos es altamente mutante

Científicos sudafricanos descubrieron otra cepa altamente mutante se trata de la variante C.1.2 es dos veces más mutante que la delta. Ya varios países tienen esta variante como Suiza, Portugal, Mauricio y Nueva Zelanda y han registrado que causa 59 mutaciones. La NIDC- Instituto Nacional de enfermedades Transmisibles de Sudáfrica anuncio el 30 de agosto este nuevo hallazgo científico.
Variante C.1.2 otra nueva cepa del Covid-19 mas mutante que las anteriores
Si bien la noticia fue lanzada hasta ahora la variante C.1.2 fue detectada en mayo en dos provincias de Sudáfrica. Las ciudades son Mpumalanga y Gauteng cerca de Johannesburgo, pero la misma está actualmente en las nueve provincias de este país. También se ha registrado la presencia de esta nueva cepa del coronavirus en Nueva Zelanda, Suiza, Portugal y Mauricio.
En estos países mencionados la variante C.1.2 ha mutado con las variantes anteriormente conocidas como la delta y la beta. Una experta científica Cathrine Scheepers de la NIDC dijo que la nueva cepa presenta “hasta 59 mutaciones, que son muchas”. Según esta científica las demás variantes suelen mutar hasta 25 veces, mientras que esta la duplica, lo que causa preocupación.
La OMS dice que no hay de que alarmarse
La Organización Mundial de la Salud OMS señala que no es catalogada como una variante de interés y mucho menos es una variante preocupante. A pesar de la alta capacidad de mutar ya que la frecuencia baja de esta variante C.1.2 es lo que importa. Y esto lo hace enfatizar otra doctora de la NIDC Jinal Bhiman, pero aún hay más datos que están estudiándose en este instante.
Datos que confirmarían o no, si es más transmisible que las anteriores variantes, según la científica señalo que están en pruebas. Acerca de la transmisibilidad “aun no lo sabemos… científicos hacen experimentos para saber más de ella”, dijo la científica. “Según nuestro propio conocimiento de las mutaciones en esta cepa, tenemos la sospecha que podría evadir de forma parcial la respuesta inmune”, subrayo.
Pero calma, la experta también dejo claro que las vacunas seguirán son también eficaces ya que seguirán ofreciendo protección contra la muerte y hospitalización. Que las vacunas Pfizer, Johnson & Johnson son muy efectivas contra esta nueva variante C.1.2 y llamo a no entrar en el pánico. Mientras que la profesora Penny Moore dijo que la variante más activa en Sudáfrica sigue siendo la delta, pues azota la tercera ola.